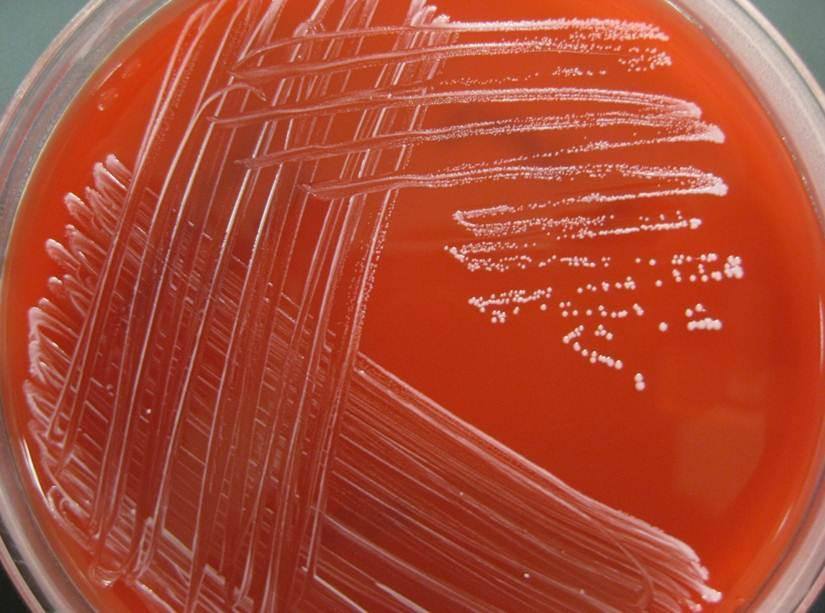

Staphylococcus epidermidis
Sinonim: Staphylococcus albus, Micrococcus epidermidis

- Gram pozitif bir bakteri türüdür.
- Deri ve mukoz florasının parçasıdır.
- Fakültatid Patojendir.Aşağıdaki olaylardan sorumlu patojendir;
- Yapay kalp kapakçıkları yüzünden Endokarditis’lerin 40 % a kadar
- Tüm Kateter’lerin 10-30 % oranında enfeksiyonundan
- 50 % Şantla ilişkili Meningitis’den
- Peritoneal dializdeki Peritonitislerin 50 %’si
- Eklem implantasyonu enfeksiyonların %50’si
- Erken doğanlardaki Sepsislerdeki önemli patojendir.
- Hastane Personeli tarafından taşınan ve hastalara aktarılan bir stafilokok türüdür.



